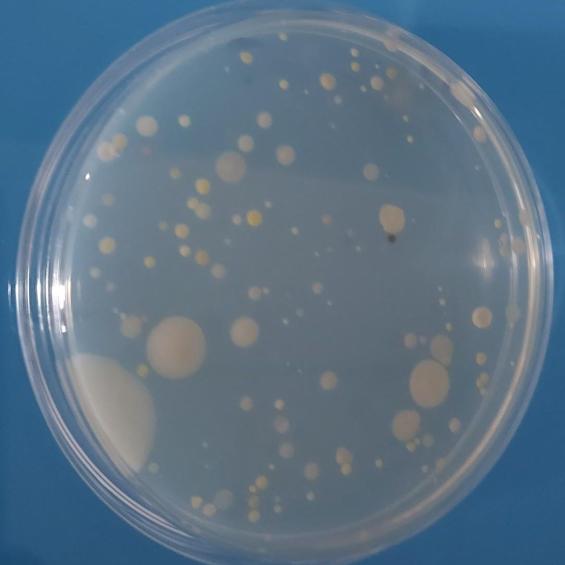
Adaptation microbienne

Le Laboratoire d'Optique et Biosciences rassemble en un lieu des compétences en biologie, en optique et en dynamique femtoseconde dans le but de favoriser l'émergence de nouveaux concepts et outils pour la compréhension du fonctionnement des molécules biologiques et de leur organisation au sein des cellules et tissus.